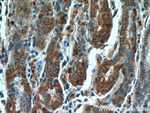
CLEC18A Antibody in Immunohistochemistry (Paraffin) (IHC (P))
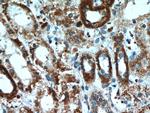
CLEC18A Antibody in Immunohistochemistry (Paraffin) (IHC (P))

Search
Proteintech
CLEC18A Polyclonal Antibody
{{$productOrderCtrl.translations['antibody.pdp.commerceCard.promotion.promotions']}}
{{$productOrderCtrl.translations['antibody.pdp.commerceCard.promotion.viewpromo']}}
{{$productOrderCtrl.translations['antibody.pdp.commerceCard.promotion.promocode']}}: {{promo.promoCode}} {{promo.promoTitle}} {{promo.promoDescription}}. {{$productOrderCtrl.translations['antibody.pdp.commerceCard.promotion.learnmore']}}
产品信息
21013-1-AP
种属反应
宿主/亚型
分类
类型
抗原
偶联物
形式
浓度
规格
纯化类型
保存液
内含物
保存条件
运输条件
产品详细信息
Immunogen sequence: ASGLWRTLQ VGWNMQLLPA GLASFVEVVS LWFAEGQRYS HAAGECARNA TCTHYMQLVW ATSSQLGCGR HLCSAGQAAI EAFVCAYSPR GNWEVNGKTI VPYKKGAWCS LCTASVSGCF KAWDHAGGLC EVPRNPCRMS CQNHGRLNIS TCHCHCPPGY TGRYCQVRCS LQCVHGRFRE EECSCVCDIG YGGAQCATKV HFPFHTCDLR IDGDCFMVSS EADTYYRARM KCQRKGGVLA QIKRQKVQDI LAFYLGRLET TNEVIDSDFE TRNFWIGLTY KTAKDSFRWA TGEHQAFTSF AFGQPDNHGF GNCVELQASA AFNWNDQRCK TRNRYICQFA QEHISRWGPG S (97-446 aa encoded by BC141808)
靶标信息
Binds polysaccharides in a Ca(2+)-independent manner with a preferentially binding to fucoidan, beta-glucans and galactans.
仅用于科研。不用于诊断过程。未经明确授权不得转售。
篇参考文献 (0)
生物信息学
蛋白别名: C-type lectin domain family 18 member A; C-type lectin domain family 18, member A; mannose receptor-like 1; Mannose receptor-like protein; Mannose receptor-like protein 2; mannose receptor-like protein 3; unnamed protein product
基因别名: CLEC18A; MRCL; MRCL1; Mrlp; MRLP2; RGD1559899
UniProt ID: (Human) A5D8T8, (Mouse) Q7TSQ1
Entrez Gene ID: (Human) 348174, (Mouse) 353287, (Rat) 307851